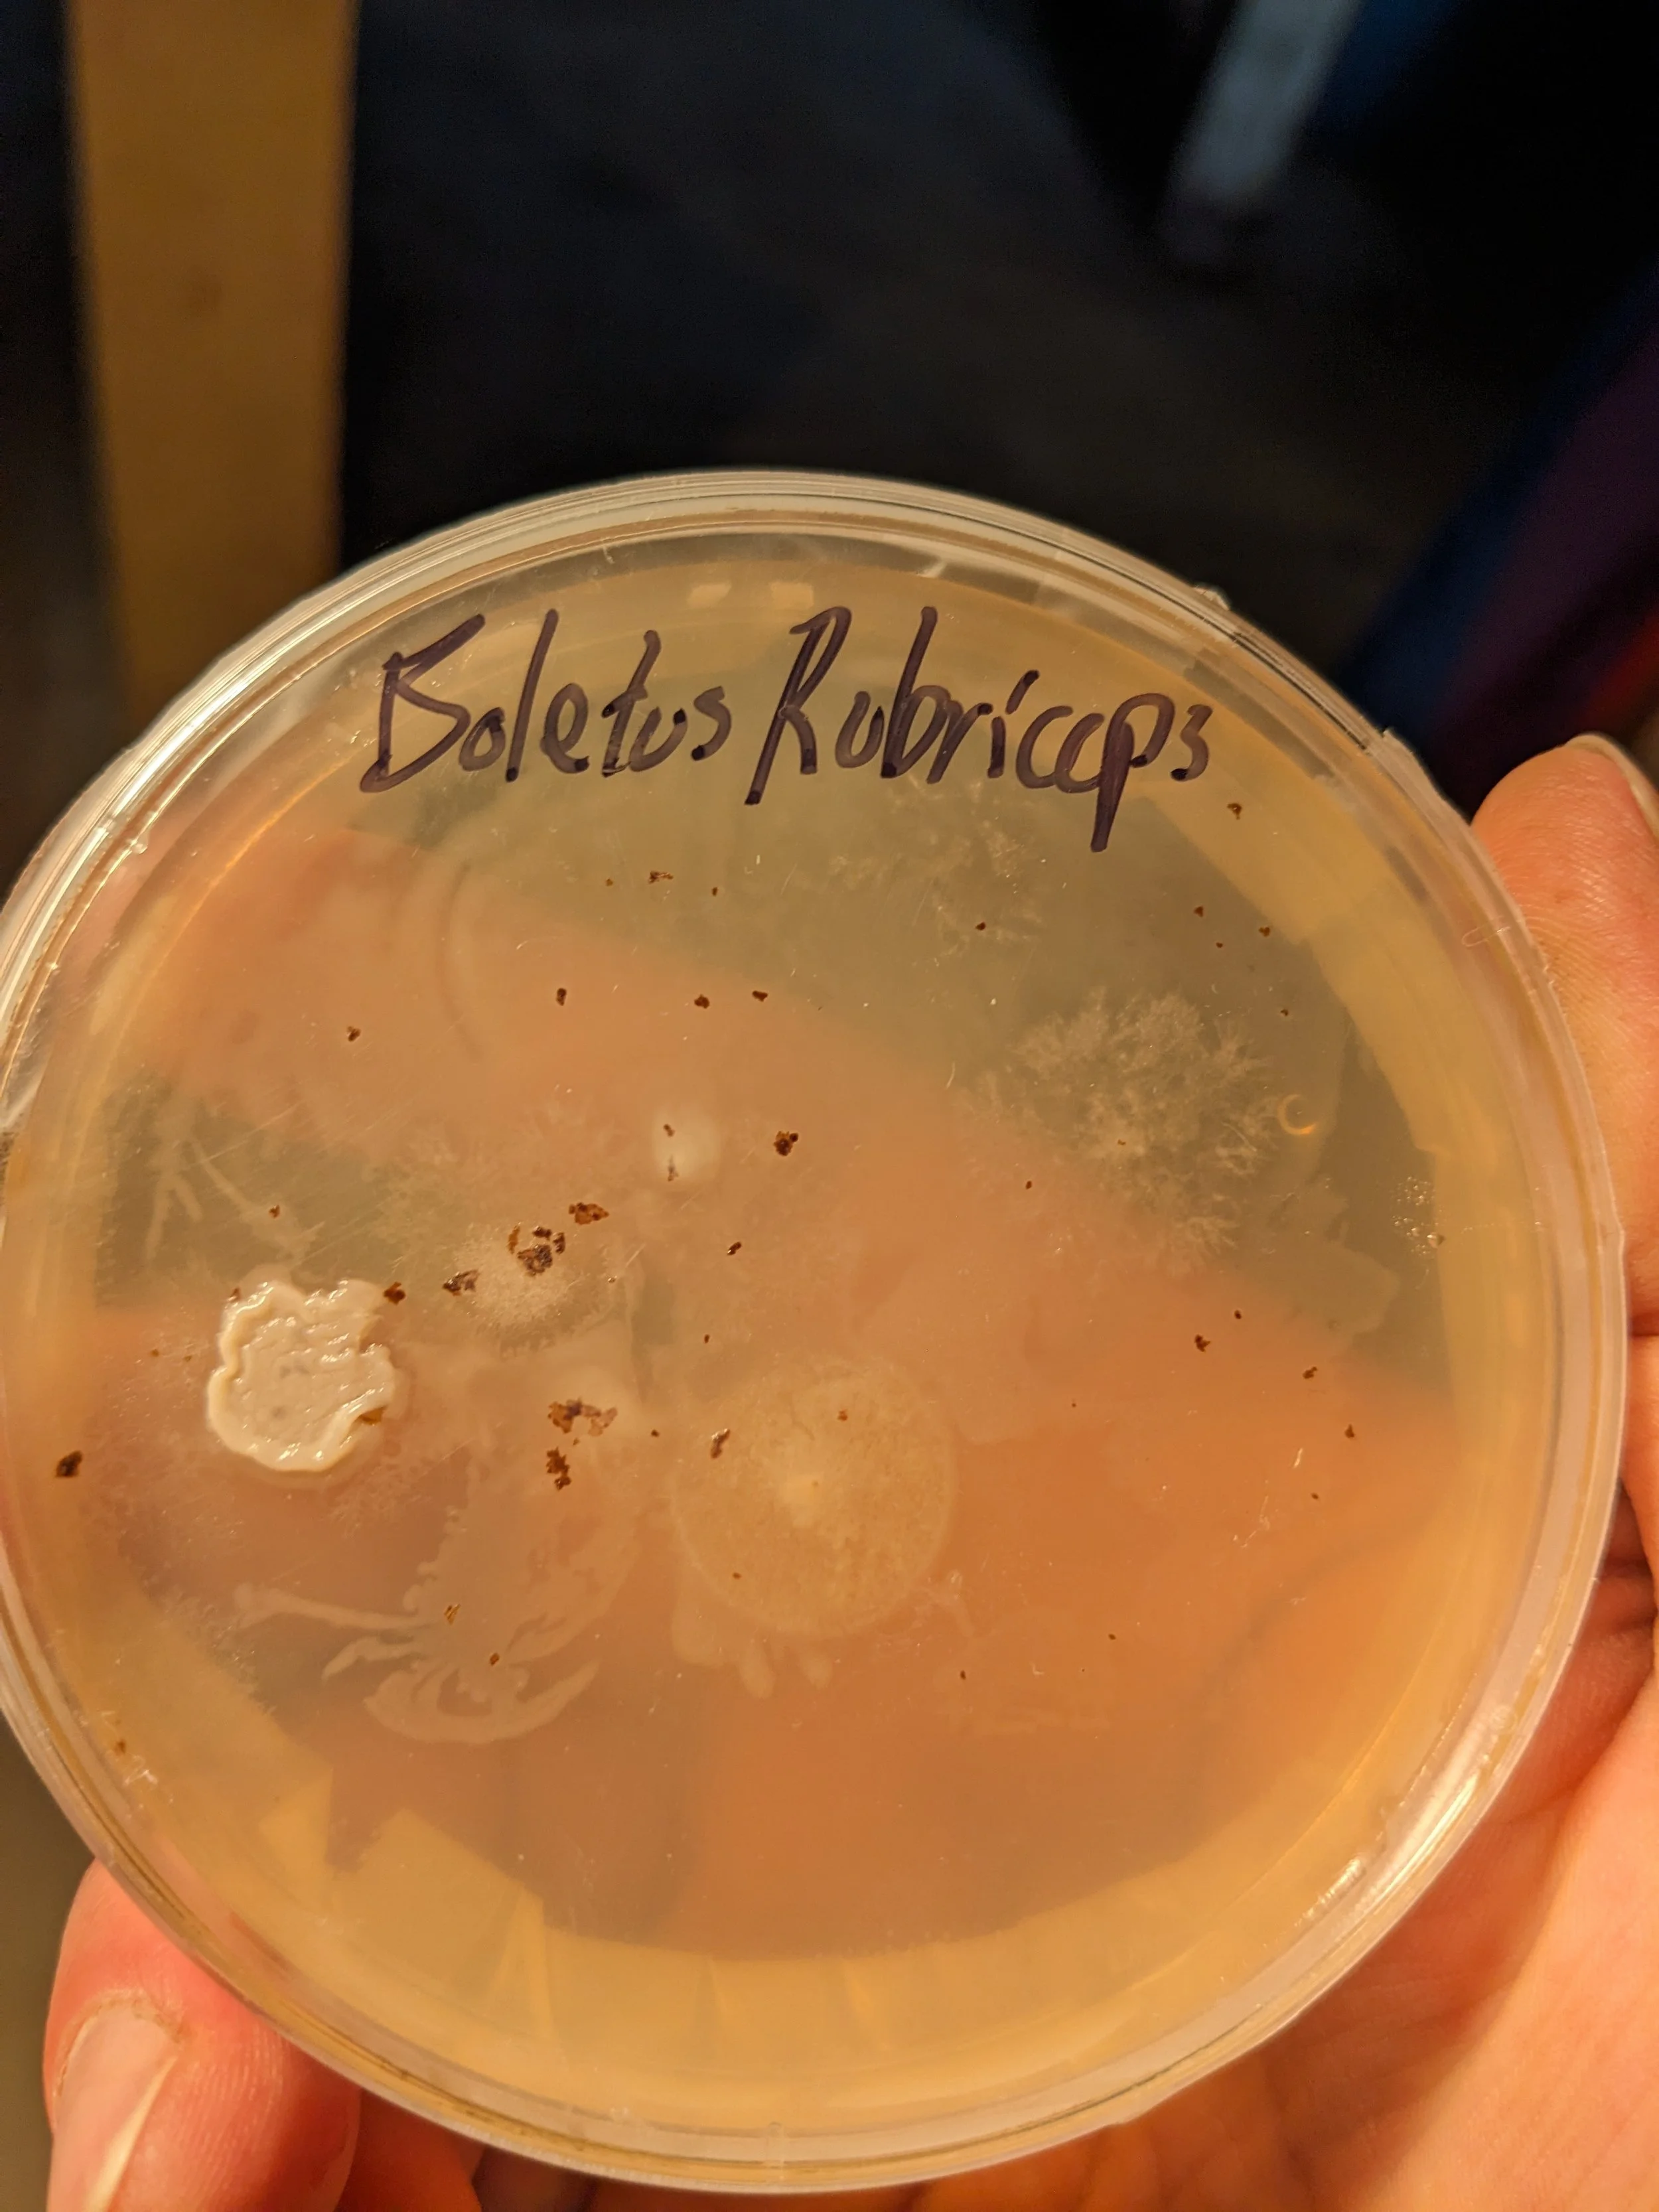
PXL_20240730_195132542.jpg

The Fourth Revolution is Here!
At Fourth Revolution Mycological Science & Supply we believe that mushrooms are a key ingredient in humanity’s future. In order to overcome the 21st Century problems of climate change, food production, and disease, we need to explore new frontiers in agricultural domestication, and mushrooms provide an untapped resource in terms of novel antiviral and antimicrobial compounds, proteins, sources of food and fiber, and even potential construction materials. Fourth Revolution Mycological focuses on acquiring rare and unique specimens from the wild, cultivating novel cultures and ecotypes through spores and cloning techniques, and making those cultures available for home growers, amateur mycologists, and the scientific and medical research communities. We also specialize in popular medicinal and edible mushroom varieties, as well as various growing supplies. Check out our Amazon Storefront for purchasing information.

What is the Fourth Revolution?
The history of agricultural domestication is constantly being refined by new archaeological and genetic discoveries, but the foundations, laid by geographer and cultural ecologist Carl Sauer in the 1920s and 30s, are solid: beginning around 15,000 years ago, the end of the last ice age resulted in dramatic shifts in weather and climate and ecosystems, forcing human beings to adapt by domesticating plants and animals they had previously hunted and gathered from the wild. This was the First Agricultural Revolution, and it allowed civilization - cities, religions, language, politics - to emerge for the first time. Since that time, various human cultures around the world at various times have domesticated around 15,000 wild species, selectively breeding and cultivating them such that they are genetically distinct from their wild cultivars. Dozens of animals species, from dogs to cormorants, have also been chosen to accompany humans on our journey to civilization.
But, it wasn’t until the late 1700s that anyone thought to try it with mushrooms! From all anthropological and archaeological evidence, humans have been consuming mushrooms for food and medicinal purposes for thousands, perhaps tens of thousands of years. Why has it taken so long for us to venture into this frontier? I started Fourth Generation Mycological, inspired by this massive lacunae - this is the future. Mushrooms represents a vast, seemingly inexhaustible genetic resource base to draw from to build a futuristic, 21st century agricultural system that not only provides food, but helps fight disease, rebuild soil fertility, reduce and recycle waste, produce fibers and building materials.
The second and third revolutions, occurring at either end of the Industrial Revolution, also resulted in massive increases in food security, increases in the human population, and a general flourishing of culture and technology. But there were consequences - we’ve pushed agricultural production to the limits, mining groundwater, polluting rivers, lakes, and oceans with agricultural chemicals and waste, and a reliance on fossil fuels and plowing and livestock have burdened the atmosphere with warming gasses. Today, in an era where climate change is again threatening the stability of our ecosystems and food production systems, about 50% of the world’s caloric intake comes from only four crops - wheat, rice, corn, and potatoes - and where 20% of the carbon in the atmosphere results from concrete, and another 20% from livestock, and where we face the constant threat of new pathogens emerging to create pandemics amidst the dwindling effectiveness of our current crop of century-old antimicrobials and antivirals, shouldn’t we look to organisms that have withstood, and thrived, through every single mass extinction event the planet has seen? Mushrooms are our ancestors, they breath oxygen and emit CO2 just like we do, and they’ve been in a multi-billion year struggle with bacteria and viruses. So, perhaps the wisdom is in the mycelium…
In 2020, amidst the COVID Pandemic, I took my lifelong hobby of mushroom hunting to the next level, applying my scientific training (PhD in Geography, University of Kansas, 2014) to this new venture. I built a mycology laboratory in my basement, experimented and became proficient at growing a variety of common mushrooms through different methods, and began collecting wild specimens with an eye towards cultivation. This is such a new and exciting field to be in - as recently as 2014, the variety of Boletus that I had been collecting in the Rocky Mountains of Colorado was officially reclassified as a unique species, rubriceps, distinguishing the more reddish, robust Rocky Mountain variety from the more common edulis. New research is constantly identifying new compounds, and scientists and clinicians search for new wild varieties to test in their labs. Discoveries are being made every day in mycology, and we are only at the very beginning. Mycology is the most overlooked and understudied aspect of biology/ecology, so I figured I’d head out into the wild and see what I could find, bring back to my lab, and bring to life!
Fourth Revolution is currently based in America’s Mycological Capital - the Pacific Northwest. We are in the process of completing our new laboratory, after having made the move from Colorado’s High Country, and have had great success in culturing several wild varieties, some of which are not currently available on the market, nor have domestication attempts been made (i.e. Sarcodon imbricatus). If you are a home grower or amateur mycologist looking for new strains to experiment with, or a clinical researcher in search of sources of specific varieties, Fourth Revolution can help you find what you are looking for!
Mycology
Filters
No results found
No results match your search. Try removing a few filters.